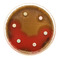

Antimicrobial resistance – a disaster in the making?
8 Jan 2016 by Evoluted New Media
After the emergence of yet another antibiotic resistance mechanism in the form of MCR-1, the future of medicine looks bleak. But there is hope says Gunnar Kahlmeter.
After the emergence of yet another antibiotic resistance mechanism in the form of MCR-1, the future of medicine looks bleak. But there is hope says Gunnar Kahlmeter.
Over the last 10–15 years the field of antimicrobial chemotherapy of bacteria, including Mycobacterium tuberculosis, is fraught with an abundance of bad news and very little good news. Bad news is in the form of rapid and accelerating antimicrobial resistance development, insufficient development of new antimicrobial agents, a continued overuse and abuse of existing agents, lack of decisive legislation to regulate the medical and non-medical use and in many places a lack of understanding of the problem.
The accelerating resistance development is in the form of i) increasing number of species harbouring resistance, ii) in each species and increasing proportion of bacteria being resistant, iii) increasing number of resistance mechanisms (and thereby genes encoding for resistance), iv) a gradual “refinement” of resistance to produce microorganisms with higher and higher MIC-values, v) an increasing number of occasions within healthcare systems across the world where multi- or extremely resistant organisms are encountered.The finding by British and Chinese colleagues of yet another new resistance mechanism – a new plasmid borne resistance, MCR-1, encoding for resistance to colistin/polymyxin, in Escherichia coli, Klebsiella pneumonia and Pseudomonas aeruginosa – adds to the bad news. And since this gene is on a mobile element, a plasmid, we’ll most likely see it in many other species soon. All these bacteria are important microorganisms in everyday health care situations. They cause blood stream infections, infections in immune-compromised hosts, serious post-operative infections and urinary tract infections. Several of these carry a high mortality when treatment fails and this time the new mechanism conveys pan-resistance in many of the isolates, rendering them impossible to treat with antibiotics.But, and here is the crux of the matter, since then modern medicine has developed in a direction where it is almost totally dependent on active antimicrobials, both antibacterial and antifungal agents.
The fact that it may have infiltrated large areas of east and south-east Asia forebodes an era where no antibiotic will be available to treat some of our patients. It is not the end of mankind and it will not bring us back to the middle ages. After all we managed to rather successfully experience the end of the Second World War without extinction as a species. But, and here is the crux of the matter, since then modern medicine has developed in a direction where it is almost totally dependent on active antimicrobials, both antibacterial and antifungal agents.
We can successfully deal with many malignant disorders, perform transplantations, perform replacement surgery with prosthetic materials and offer neonatal and other intensive care. All of these procedures require us to prevent or treat complications in the form of severe infections developing while our immune response is affected by the disease, the medication or both. If pan-resistance – i.e. resistance to all antimicrobials – becomes common we may have to re-evaluate our strategies when dealing with these disorders and procedures.
Two distinctive problems emerge when resistance becomes common. The first, and easiest to understand, is that when microorganisms develop resistance to most, or all, antimicrobials it becomes impossible to successfully treat the infections. The second problem is related to the fact that most antimicrobial therapy is blind. When therapy is instituted, it is not known which organism causes the problem. Therapy is empirical, i.e. based on experience from identical or similar situations, and it is assumed that the chosen therapy will see the patient over the difficult patch and that once cultures have been analysed and the cause and susceptibility pattern are known therapy can be targeted. However, as resistance increases, the probability of failure increases and the clinician loses his confidence and decides to play it safe. This will be in the form of changing empirical therapy from cheaper more targeted agents to broader and more expensive agents. This behaviour will further drive resistance. The alternative is risking the life of the patient.What did we do to deserve this? Mankind behaved the way we behave with most natural resources available to us. We have abused antibiotics since we discovered them and we continue to squander them for economical gain in areas where antibiotics have no place at all. We look for and quibble over evidence that using 600 tons of antibiotics to successfully rear pigs is not harmful, instead of saying “why take the risk”? In the latest case, that of the new gene MCR-1 encoding resistance to colistin/polymyxin, it is now believed that the frequent use of colistin in animal husbandry in China and other east Asian countries may be behind the catastrophe. Evolution is a harsh but fair task master. We deserve everything we get. We are risking our lives but sadder still, we have squandered the resources of our children and grandchildren.
Any light at the end of the tunnel? In truth there are positive signals, several of which I list below. The problem is that the negative findings, such as the discovery of new resistance genes and mechanisms, the spread of multiresistance, and the lack of decisive measures from society, outweigh the good news and the balance is not promising.
We have abused antibiotics since we discovered them and we continue to squander them for economical gain in areas where antibiotics have no place at all.
Some of the positive signals include the fact that development of rapid diagnostics is making real progress and it may be that in the future we will not need to give empiric therapy. It will be of little comfort to those infected with pan-resistant organisms, but to all others it will be helpful and also it will help save the really valuable antimicrobials by delaying resistance development. Also, in a few countries the trend to always use more antibiotics year on year has been stayed – this will so far not affect the real numbers but will serve as role models for others.
Some legislative measures have also been taken or are planned to reduce the use of antimicrobials in agriculture and animal husbandry. It is also true that we are gradually becoming better at measuring and comparing resistance between countries and both national and supranational (ECDC, WHO) initiatives are in place. Methods to measure resistance have also been harmonised to a great extent; up till recently there were at least seven methods. Breakpoint committees have also now been reduced to just two: EUCAST and CLSI. An abundance of networks “to combat antimicrobial resistance” have been formed and all aim to help to raise the awareness, not least during Antibiotic Awareness Day on the 18th of November each year.
Author: Gunnar Kahlmeter is a Communications Officer for the European Society of Clinical Microbiology and Infectious Disease and a key figure of the European Committee on Antimicrobial Susceptibility Testing.